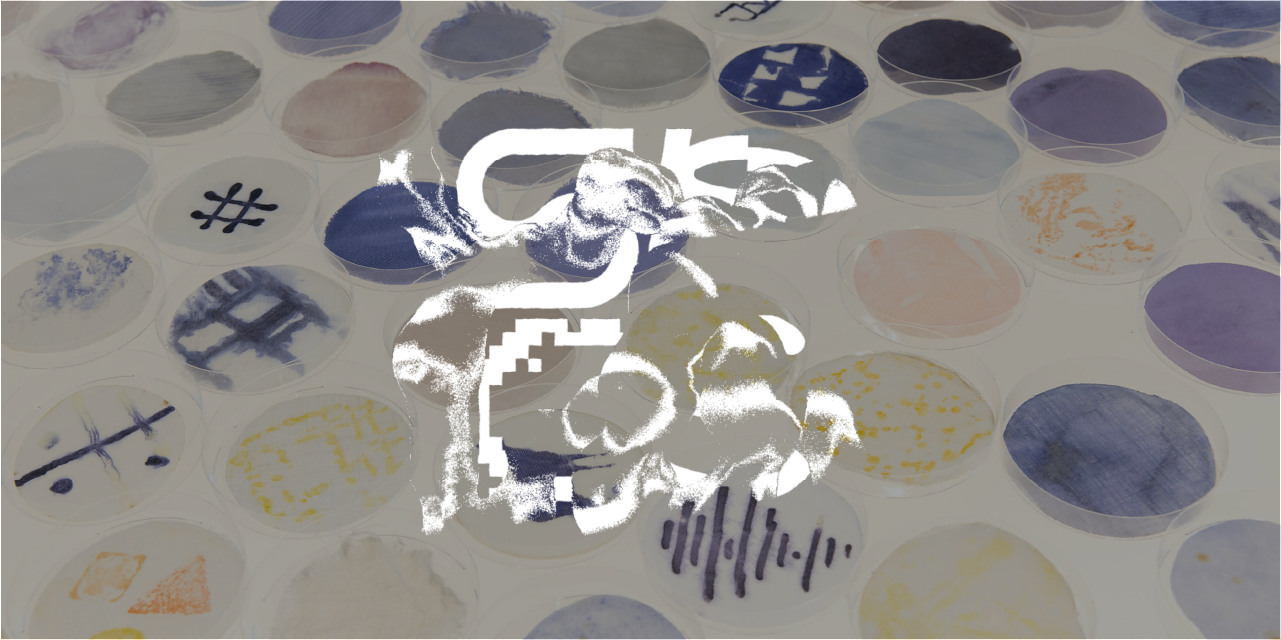

Exhibition
- #Finished
- #Entrance Free
Bacteria are all around (and in) us, yet invisible to the naked eye. Now they are made visible in this exhibition through the colourful pigments they produce. This may be a new way for the textile industry to create colour that is not pollutive. Join us to explore a new world of co-creating and co-designing textiles and garments with bacteria.
Sun, April 16, 2023 – Sun, April 23, 2023 UTC+09:00
FabCafe Tokyo | View on Google Map
Free
Growing Colour: Replacing traditional textile dyes with living bacteria
Textile dyeing is the second largest polluter of water globally, leaving rivers black and toxic in many garment-producing areas. The synthetic dyes and finishes are often conveniently dumped into waterways, despite the known hazards.
What if there was a way to colour our clothes without such toxic waste production? A new form of dyeing promises to reduce both chemicals and water usage, but it requires us to rethink colour. Instead of a non-living resource to be used and controlled by humans, the colour that Julia Moser works with is living, growing bacteria.
Julia Moser founded the Growing Patterns Living Pigments project, which explores the use of bacterial pigments to dye textiles in different colors, shapes and patterns. The results allow us to ‘see’ the usually invisible bacteria as they stain the fabrics in a variety of colours. Not only does this method not use any chemical dyes but it also reduces the amount of water needed.
Fabric stained directly by bacteria and yarns dyed with the bacteria to use for knitting or weaving. (Photos by Julia Moser)
How do we incorporate unpredictable outcomes into our design?
Yet, as living organisms, we do not control exactly their movement and growth. How do we work with these bacteria in ways that produce desirable designs? In a cut-throat industry focused on mass-production with little regard for the environment, how do we make space for nature to design and create alongside us?
That is the key to Moser’s work. She actively invites bacteria to co-design and determine the outcome of her garments. This spring, her work will be exhibited in FabCafe Tokyo and we invite you to explore the possibilities of co-creating fashion with bacteria.
Exhibition Outline
Textile Samples
・Acrylic Mounted Process Samples
・Bacteria dyed textile samplesGarments
・Knitwear ‘instructed’ by bacteria growth
・Jacket with pattern-cutting decided by bacteria growth
-

Knit sweater where the knit pattern was dependent on the shades of colour created by the bacteria, creating a haptic pattern.
-

Jacket cut according to shapes that bacteria left on the fabrics.
Microbiomes, radiation, viruses, bacteria – these uncontrollable forces of nature are often dismissed as errors or dangerous. However, can we reclaim the view of this uncontrollable biodiversity and propose a new positive way of creatively designing for and with these ‘errors’? That is the purpose of the community SPCS.
SPCS is a program that explores new ways of co-creation with nature through prototyping. “In what ways can we work with the uncontrollable power of nature and design systems that promote creativity?” Is our guiding question. Each season, we invite lecturers from different fields to carry out practical workshops. Instead of manipulating nature for our human needs, we explore a co-creationary approach. We encourage a speculative output formed by each participant’s curiosity towards biological mechanisms.
Activity Concepts / Past activities >>
SPCS|A Community Exploring Biological Design
-
Growing Patterns Living Pigments
The ongoing project GROWING PATTERNS. LIVING PIGMENTS by studio LIA sees its mission in re-thinking fashion and textile design practices and production processes towards a more sustainable and healthier future. New technologies are being used to find alternative ways of thinking about fashion. While the dyeing industry is seen as the biggest environment polluter in the production chain, a focus lies on bacteria dyeing, which brings numerous advantages over traditional dyeing techniques. The goal is to generate a broader application field for this technique and to find new ways of using bacteria for the dyeing of fabrics and filtering water after the dyeing process. In combination with techniques like UV and 3D-printing, laser engraving and -cutting as well as jacquard weaving, silk screening and so on, the first phase of the project made it possible to push bacteria dyeing a step forward in terms of aesthetics. In an artistic research process the growth of the bacteria could be guided and pattern designs were able to establish, which is a great achievement for being able to compete with other printing and dyeing methods.
The ongoing project GROWING PATTERNS. LIVING PIGMENTS by studio LIA sees its mission in re-thinking fashion and textile design practices and production processes towards a more sustainable and healthier future. New technologies are being used to find alternative ways of thinking about fashion. While the dyeing industry is seen as the biggest environment polluter in the production chain, a focus lies on bacteria dyeing, which brings numerous advantages over traditional dyeing techniques. The goal is to generate a broader application field for this technique and to find new ways of using bacteria for the dyeing of fabrics and filtering water after the dyeing process. In combination with techniques like UV and 3D-printing, laser engraving and -cutting as well as jacquard weaving, silk screening and so on, the first phase of the project made it possible to push bacteria dyeing a step forward in terms of aesthetics. In an artistic research process the growth of the bacteria could be guided and pattern designs were able to establish, which is a great achievement for being able to compete with other printing and dyeing methods.
-
Date & Time
-
Sun, April 16, 2023 – Sun, April 23, 2023 UTC+09:00
-
Venue
-
FabCafe Tokyo
150-0043 Dogenzaka, Shibuya-ku, Tokyo 1-22-7 Dogenzaka Pier 1F
tel. 03-6416-9190
https://fabcafe.com/jp/tokyo/
View on Google Map -
Fee
-
Free





